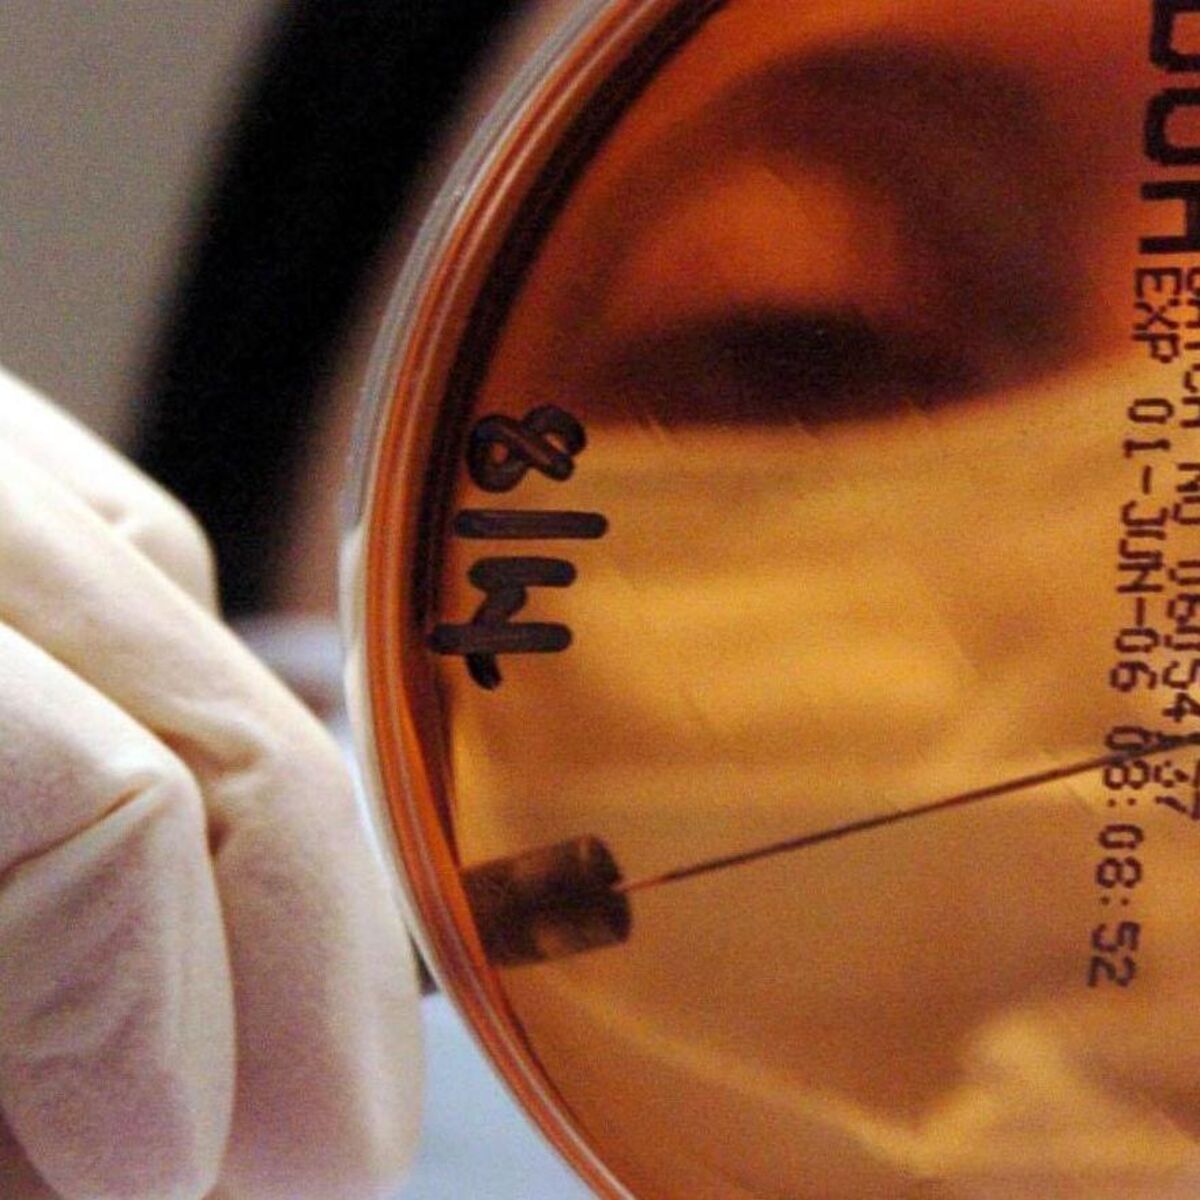
Compulsory housing order issued to halt spread of bird flu

Copyright irishexaminer
Bird flu, which causes the disease is known as HPAI H5N1, has been in circulation among wild birds over the past year, with 40 cases confirmed by the Department of Agriculture. Outbreaks have also been reported in the UK and EU in recent weeks. On Wednesday, an outbreak of a "highly pathogenic" strain of bird flu was confirmed at a commercial turkey flock in County Carlow, leading to the Department of Agriculture imposing a 3km protection zone and 10km surveillance zone around the affected area. The farm is understood to have a flock of around 500 turkeys. On Tuesday, Fota Wildlife Park confirmed it will remain closed to the public until at least the end of November after an outbreak of bird flu last month. Twelve cases have been confirmed at the park since the outbreak began. The park has been closed since October 14. Agriculture Minister Martin Heydon said the nationwide compulsory housing order for poultry and captive birds was being put in place due to "the increased risk of avian influenza to our poultry", and to reduce the threat it poses "to our industry and to our poultry farmers’ livelihoods". From Monday, poultry and captive birds must be housed or confined in such a manner that they do not have access to other poultry, captive birds, or wild birds. "Reducing the opportunity for contact with potentially infected wild birds, is crucial as this is one of the main ways in which the virus can spread," the minister said. Mr Heydon said biosecurity remains "the single most effective way to prevent the virus spreading from wild birds into poultry, or between poultry flocks". "All those who have poultry or kept birds must take strict precautions and exercise the highest standards of biosecurity to protect their flocks from the threat of avian influenza, and to protect the poultry sector in Ireland," he said. While avian influenza can be very contagious between birds, but health authorities have advised the risk to public health from the strain of Avian Influenza currently circulating is very low. Strict new biosecurity regulations for poultry have been in place since last Saturday, and all bird owners are being warned to be vigilant for signs of disease in their flocks which vary between species but can include: swollen head; discolouration of neck and throat; loss of appetite; respiratory distress; diarrhoea; and fewer eggs laid. Members of the public are advised not to handle sick or dead wild birds and to report any episodes of sick or dead wild birds to their Regional Veterinary Office or, if outside business hours, to contact the National Disease Emergency Hotline on 01 492 8026. The Department of Agriculture says it is continuing to "closely monitor and assess the disease situation and is in regular contact with industry stakeholders and counterparts in Northern Ireland".



